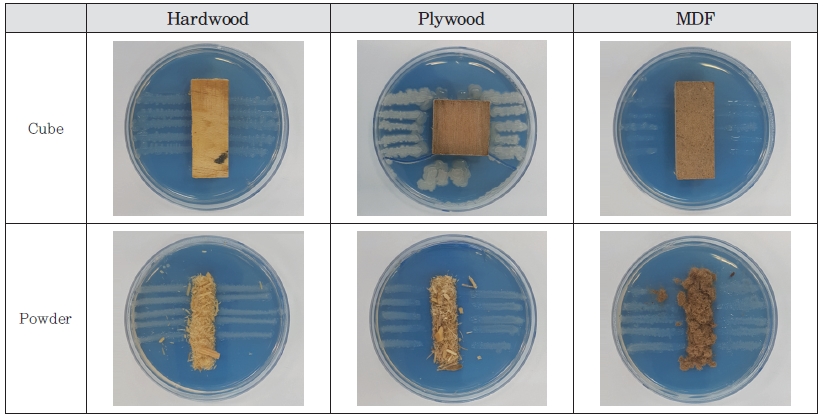
https://cdn.apub.kr/journalsite/sites/ktappi/2018-050-06/N0460500607/images/JKTAPPI_2018_v50n6_54_f006.jpg

1. 서 론
1인 가구의 증가, 삶의 질 향상으로 인하여 가구시장은 지속적으로 증가하고 있다. 이에 따라 가구의 원재료 MDF, 합판, PB의 사용 역시 증가하고 있다.1) 환경부 통계에 의하면 2016년 폐목재 발생량은 194만 톤으로 이 중 생활계 폐목재는 28%에 해당하는 55만 톤이다. 하지만 생활계 폐목재는 재활용 비율이 32% 로 사업장 생활계 90%, 사업장 배출 시설계 91%, 건설계 폐목재 95%에 비하여 재활용 비율이 낮다.2) 이처럼 생활계 폐목재의 재활용 비율이 높지 않은 이유는 폐목재 선별기술이 미비하고 대부분이접착제를 도포해 건조 및 성형과정을 거쳐 열압 제조된 MDF, 합판, PB이기 때문이다.3) 이렇게 접착제가 도포된 MDF, 합판, PB는 폐목재의 분류 및 재활용기준에서 2, 3등급으로 분류되고 비료관리법에서는 1등급 폐목재와 같이 퇴비 제조 시 수분조절제로 톱밥으로의 사용이 불가능하다. 그래서 폐 MDF, 합판을 재생 MDF, PB로 재활용하는 방법이 있지만 물성을 측정하였을 때 휨성질과 박리강도가 낮게 나타나며 포름알데히드 방출량이 높기 때문에 재활용이 어렵다.4-6) 이처럼 재활용이 쉽지 않은 MDF, 합판, PB 생활계 폐목재는 59% 가 소각되거나 매립되고 있다. 하지만 소각 시 유독가스 즉 다이옥신류(PCDD/Fs)가 발생되며 MDF의 경우 NO2는 치사농도 250 ppm보다 높은 408.7 ppm, SO2는 치사농도 400 ppm보다 2배가 높은 807.3 ppm 발생되어 대기 오염의 원인이 되기도 한다.7,8) 또한 경제성 및 환경성을 평가, 계산하였을 때 물질 재활용, 재사용이 비용 대비 편익이 높았으며 소각에는 비용 대비 편익이 낮은 것으로 나타났다.9)
본 연구에서는 2, 3등급 폐목재의 이용을 소각이 아닌 퇴비화 방법을 통해 재활용 가능성을 규명하는 데 목적을 두었다. 앞서 Arias의 연구에서 MDF를 축분과 함께 퇴비화 한 사례가 있듯이 2, 3등급의 폐목재의 퇴비화 가능성이 있다고 판단되었다.10) 그래서 1등급의 원목과 2, 3등급의 MDF, 합판을 KS M ISO 14855-1 규격에 준용하여 실험을 통해 일정 기간 동안 호기성 퇴비화 조건과 생분해도 측정 방법을 이용하여 이산화탄소 발생량 적정을 통한 생분해도 측정을 실시하였다.11) 검증 방법으로는 SEM과 생물학적으로 미생물 시험으로 검증하였다. 생분해도 실험은 117일간 실시되었으며, 동일 기간 동안 표준시험물질은 TLC(thin-layer chromatography)급 cellulose도 같이 실험을 실시하였다. 그리고 생분해 시험 시작 전, 후의 목질 재료의 표면을 SEM을 통해 관찰하였으며 생물학적 방법으로 희석평판배지 도말법, carboxymethyl cellulase 선택배지를 이용한 cellulase 활성 측정, ATCC 147 평행선 구획법을 통해 접착제에 대한 미생물의 저항성을 측정하였다.12)
2. 재료 및 방법
2.1 공시재료
본 연구에 사용된 공시재료는 가구에 사용하는 라디에타 파인 원목, S 社로부터 분양받은 거푸집용 합판, D社로부터 분양받은 중밀도섬유판(MDF: medium density fiberboard)을 사용하였으며 생분해도 측정 시 내경 1.6 mm sieve로 거른 뒤 사용하였다.
2.2 실험방법
2.2.1 포름알데히드 방출량 분석
제조된 중밀도 섬유판의 포름알데히드 방출량은 시험방법 KS M 1988: 2009에 의거하여 데시케이터법으로 측정하였다.
2.2.2 이론적 이산화탄소 발생량 측정
이론적 이산화탄소 발생량을 측정하기 위하여 건조 고형분, 휘발성 고형분, TOC를 측정하였다. 건조 고형분은 105℃에서 1시간 이상 건조, 휘발성 고형분은 Furnace 550℃에서 3시간 이상 처리, TOC 분석은 analyzer N/C 3100, Jena, Germany로 TC(total carbon) 측정을 실시 이후, TIC(total norganic carbon)를 측정하여, TOC 값을 Eq. 1과 같은 방법으로 계산하였다.
2.2.3 목재제품의 생분해도 측정
생분해도 평가는 KS M ISO 14855-1 퇴비화 조건에서 플라스틱 재료의 호기적 생분해도 측정: 이산화탄소 분석에 의한 방법 - 제 1부 일반적 방법으로 퇴비화 조건을 규명하기 위한 실험을 실시하였다. 본 시험 방법은 가상의 호기성 퇴비화 과정에서 시험 물질의 생분해도 및 붕괴도를 측정하는 방법이다. 생분해도는 시험 물질의 이론적 이산화탄소 발생량과 실제 시험 물질로부터 발생하는 이산화탄소량의 비율로 결정하며, 이산화탄소의 최대 이론적 발생량은 물질의 총 유기 탄소의 함유량으로부터 계산하였다.
생분해도 계산은 Eq. 2와 같은 방법으로 계산하였다.
(CO2)T : 시험 물질이 담긴 퇴비화 용기로부터 발생한 이산화탄소의 누적량(g)
(CO2)B : 접종원 용기로부터 발생하는 이산화탄소 누적량의 평균(g)
ThCO2 : 용기 속 시험 물질에 의해 발생하는 이론적 이산화탄소의 양(g)
2.2.4 전자현미경 관찰
전자현미경 관찰에는 Energy Dispersive X-Ray (EDX) Spectroscopev, TESCAN, Czech를 이용하였으며, 배율은 200, 500, 1,000, 2,000배로 설정하여 표면을 관찰하였다.
2.2.5 퇴비 미생물 개체수 측정
퇴비에 있는 미생물의 활성 차이를 분석하기 위하여 생물학적 분석을 실시하였으며, 분석 방법으로 희석 평판법을 실시하였다. 최초 0.85% NaCl 생리 식염수 제조하였고, 시료 1 g을 섞어 각각 10배씩 희석하여 NA 배지에 1 mL씩 접종하여 37℃에서 24시간 배양한 후 미생물의 개체수를 확인하였다.
2.2.6 Cellulase 활성도 측정
퇴비에서 분리한 미생물의 cellulase 활성 차이를 분석하기 위하여 생물학적 분석을 실시하였으며, 분석 방법으로 CMC 고채배지(carboxyl cellulose 10 g, Tryptone 2 g, KH2PO4 2 g, Na2HPO4 4 g, MgSO4·7H2O 0.2 g, CaCl2·2H2O 0.001 g, FeSO4·7H2O 0.004 g, Agar 15 g)를 제조하여 균주를 접종 후 24시간 배양한 후 Congo Red 용액으로 염색하였다. 이후 NaCl 용액으로 탈색 후 clear zone을 확인하였다.
2.2.7 할로테스트
할로테스트는 AATCC 147, KSK0890: 텍스타일 재료의 항균성 시험방법: 평행 구획선법으로 각각의 목재 재료 및 접착제에 대한 항균성 및 저항성을 측정하기 위한 실험을 실시하였다.
3. 결과 및 고찰
3.1 공시재료의 포름알데히드 함량
포름알데히드(HCHO) 방출량의 결과 KS 제품 기준으로 MDF 0.4 mg/L로 E0급, 합판 1.2 mg/L로 E1급의 수준으로 나타났다.
3.2 이론적 이산화탄소 발생량
이론적 이산화탄소 발생량을 계산하기 위하여 실험 대상 물질들의 기본 물성인 건조 고형분, 휘발성 고형분, TOC를 건조기, Furnace, TOC analyzer를 이용하여 측정하였으며, 그 결과값을 근거로 이론적 이산화탄소 발생량(theoretical amount of evolved carbon dioxide; ThCO2)을 계산하였으며, 그 결과는 Table 1과 같다.
Table 1.
Theoretical amount of evolved carbon dioxide (ThCO2) of cellulose and Wood Materials
| Item | Total dry solids (%) | Volatile solids (%) | TOC (%) | Organic carbon ratio CTOT (g/g) | ThCO2 (g/vessel) |
|---|
Compared to the dry | Compared to the wet |
|---|
| Cellulose | 98.72 | 99.96 | 98.68 | 45.5 | 0.45 | 27.33 |
| Hardwood | 96.73 | 86.80 | 83.97 | 54.4 | 0.54 | 32.00 |
| Plywood | 97.62 | 81.05 | 79.13 | 50.9 | 0.51 | 30.23 |
| MDF | 97.23 | 82.69 | 80.40 | 52.9 | 0.53 | 31.31 |
3.3 생분해도
생분해도 평가 결과는 Table 2, Fig. 1에 나타내었다. 본 연구에 사용된 원목, 합판, MDF의 이산화탄소 방출량에 의해 계산된 평균 생분해도는 각각 44.4%, 26.8%, 58.6%이었고 표준물질인 셀룰로오스는 96.5%로 나타났다. 특히 MDF의 경우 생분해도는 원목보다 높은 생분해도를 나타내었다. 이것은 섬유화로 인하여 분해가 빠르게 나타났기 때문이며 사용된 접착제 성분이 시간이 지남에 따라 퇴비의 수분 및 미생물, 곰팡이에 의하여 해리되어 MDF가 섬유화됨으로써 표면적이 넓어져 생분해도가 향상되는 것으로 사료된다.13) 합판의 경우 원목에 비하여 포름알데히드가 높고 퇴비 미생물에 저항성을 갖기 때문에 생분해도가 낮게 나타났다.14)
Table 2.
Biodegradable test result of Wood Materials
| Item | Biodegradability (%) | Test period (day) |
|---|
| Cellulose | 96.5 | 117 |
| Hardwood | 44.4 | 117 |
| Plywood | 26.8 | 117 |
| MDF | 58.6 | 117 |

Fig. 1.
Curve of biodegradability of Wood Materials.
3.4 SEM 촬영
Fig. 2는 원목, 합판, MDF의 표면을 SEM으로 관찰한 결과이며 Fig. 3은 원목, 합판, MDF의 생분해도 시험이 끝난 후 표면을 SEM으로 관찰한 결과이다. 목질 재료들이 표면 침식이 일어나고 미세공극이 커지는 것을 원목, WPC의 Nasser 결과와 같이 명확히 관찰할 수 있었다.15) 특히, 원목, MDF의 경우에 더욱 현저하게 표면 침식이 나타났는데 이것은 합판보다 포름알데히드 방산량이 낮고 퇴비에서 enzymatic hydrolysis 과정을 발생시켜 목재의 셀룰로오스 성분을 주로 파괴했다고 판단된다.16,17)

Fig. 2.
Scanning electron micrographs of initial Wood Materials.

Fig. 3.
Scanning electron micrographs of after 117 days Wood Materials.
3.5 퇴비 미생물 개체수 측정
퇴비의 미생물로 본 활성 평가는 117일 생분해 시험이 종료된 퇴비를 희석평판 방법에 따라 시험을 하였고 그 결과를 Fig. 4에 나타내었다. 생분해도 시험에 원목, 합판, MDF의 미생물 개체수는 각각 2.6×105, 1.5×105, 3.3×105 cfu/g으로 생분해도와 비례한 결과를 나타냈다.

Fig. 4.
Microbial population of compost by Wood Materials.
3.6 Cellulase 활성도 측정
퇴비에서 분리한 결과 Jeanine, Olja와 같은 미생물 Bacillus licheniformis, Bacillus subtilis, Bacillus megaterium이었다.18,19) Cellulase 활성은 clear zone 확인 결과 Fig. 4와 같이 나타났다. 그 결과 Bacillus licheniformis, Bacillus subtilis에서 cellulase 활성도가 나타났으며 Bacillus licheniformis에서 가장 많이 나타났다. Bacillus licheniformis, Bacillus subtilis는 산업용 효소 생산에 사용되고 있고 Bacillus licheniformis는 NAD (P) 의존성 알데히드 탈수소 효소를 갖고 있는 미생물로 알려져 있다.20)

Fig. 5.
Detection of cellulase activity of Microorganisms.
3.7 할로테스트
Cellulase의 활성이 가장 뛰어난 미생물 Bacillus licheniformis로 본 할로테스트 결과를 Table 3, Fig. 6에 나타내었다. 할로테스트 결과 원목에는 미생물의 저항성이 없었으며 접착제가 사용된 합판, MDF의 경우 저항성이 나타났다. 하지만 MDF의 경우 분쇄하였을 경우 저항성이 낮아지는 결과를 나타냈으며 Fig. 7과 같이 접착제의 포름알데히드가 작용을 하였기 때문이다.21) 이와 같은 결과는 목재 부후균과 포름알데히드의 관계에서 포름알데히드양이 증가할수록 부후균의 성장이 반비례하는 결과처럼 유사한 결과를 나타냈다.14)
Table 3.
Halo tests with Bacillus licheniformis of Wood Materials
| Cube | Halo result (mm) | Powder | Halo result (mm) |
|---|
| Hardwood | 0 | Hardwood | 0 |
| Plywood | 5 | Plywood | 7.5 |
| MDF | 10 | MDF | 1 |
Fig. 6.
Halo tests with Bacillus licheniformis of Wood Materials.

Fig. 7.
Hallo test result of cellulose and Adhesives.
4. 결 론
본 연구에서는 폐목재를 퇴비화 및 생물학적 분석을 통해 비교·분석하였다. 연구 결과를 요약하면 다음과 같다.
1. 생분해도는 MDF 〉원목 〉합판 순으로 나타났다.
2. 퇴비의 미생물 개체수를 측정한 결과 생분해도와 비례하게 MDF 〉원목 〉합판 순으로 나타났다.
3. SEM 촬영 결과 시간이 지남에 따라 목질 재료의 표면이 침식된 것을 볼 수 있었다.
4. 퇴비에서 분리한 Bacillus licheniformis, Bacillus subtilis, Bacillus megaterium의 cellulase 활성도 측정 결과 Bacillus licheniformis, Bacillus subtilis에서 활성도가 있는 것으로 나타났으며 clear zone의 크기로 보았을 때 Bacillus licheniformis가 가장 활성도가 큰 것으로 나타났다.
5. Cellulase 활성도가 가장 큰 Bacillus licheniformis로 할로 테스트를 측정한 결과 MDF를 분쇄하였을 때 저항성이 감소하는 것을 나타냈으며 접착제의 포름알데히드에 의해 미생물들의 저항성을 나타내는 것을 알 수 있었다.
이 결과로 폐 목질 재료의 퇴비화 과정 중 포름알데히드 감소에 필요한 전처리에 대한 연구가 필요하며 E0의 MDF의 경우 퇴비화가 가능하며 폐목재의 자원화가 용이할 것으로 기대된다.
Acknowledgements
본 연구는 산림청(한국임업진흥원)산림과학기술 연구개발사업(2014068D10-1819-AA03) 지원 연구비를 받아 수행하였음.
Literature Cited
2016 Furniture Industry Competitiveness Survey, Ministry of Commerce, Industry and Energy.
2016 Furniture Industry Competitiveness Survey, Ministry of Commerce, Industry and Energy.
National Statistical Office, (2016)
National Statistical Office (2016).
S. M. Lee, E, C. Kang and J, Y. Park, A study on the status and improvement of adhesives for domestic MDFKorea Furniture Society, Spring Conference; 93-96 (2007)
Lee, S. M., Kang, E, C., and Park, J, Y., A study on the status and improvement of adhesives for domestic MDF, Korea Furniture Society, Spring Conference, pp. 93-96 (2007).
H. H. Lee, I, S. Seo, Y. M. Cho and H. S. Park, Journal of the Korea furniture Society,
Manufacture of high density fiberboard from disintergrated and beaten MDF waste,
17(1); 64-71 (2006)
Lee, H. H., Seo, I, S., Cho, Y. M., and Park, H. S., Manufacture of high density fiberboard from disintergrated and beaten MDF waste, Journal of the Korea furniture Society 17(1): 64-71 (2006).
J. S. Suh, T. H. Han and J, Y. Park, KFRI. J. For. Sci,
Hammermilled characteristics of recycled wood particles and properties of boards by mixing of urban waste wood particles,
69; 131-138 (2006)
Suh, J. S., Han, T. H., and Park, J, Y., Hammermilled characteristics of recycled wood particles and properties of boards by mixing of urban waste wood particles, KFRI. J. For. Sci. 69:131-138 (2006).
S. B. Park, S. M. Lee, J, Y. Park and E. C. Kang, Journal of the Korea Furniture Society,
Properties and formaldehyde emission of particleboards fabricated with waste wood charcoal,
18(3); 205-210 (2007)
Park, S. B., Lee, S. M., Park, J, Y., and Kang, E. C., Properties and formaldehyde emission of particleboards fabricated with waste wood charcoal, Journal of the Korea Furniture Society 18(3):205-210 (2007).
N. C. Kim and J. I. Lee, Journal of the Korean Society for Environmental Analysis,
Emission characteristics of PCDDs/DFs and gaseous matter from waste wood incinerators,
14(4); 213-220 (2011)
Kim, N. C. and Lee, J. I., Emission characteristics of PCDDs/DFs and gaseous matter from waste wood incinerators, Journal of the Korean Society for Environmental Analysis 14(4):213-220 (2011).
J. B. Kim and S. Y. Lee, Journal of the Korean Wood Science and Technology,
The combustion gas hazard assessment of main building materials,
44(5); 639-654 (2016)
Kim, J. B. and Lee, S. Y., The combustion gas hazard assessment of main building materials, Journal of the Korean Wood Science and Technology 44(5):639-654 (2016).
10.5658/wood.2016.44.5.639A study on the generation of waste furniture and collection and distribution system, Ministry of Environment. (2015)
A study on the generation of waste furniture and collection and distribution system, Ministry of Environment (2015).
O. Arias, S. Viña, M. Uzal and M Soto, Journal of Science of the Total Environment,
Composting of pig manure and forest green waste amended with industrial sludge,
586; 1228-1236 (2017)
Arias, O., Viña, S,. Uzal., M. Soto, M,, Composting of pig manure and forest green waste amended with industrial sludge, Journal of Science of the Total Environment. 586:1228-1236 (2017).
10.1016/j.scitotenv.2017.02.118Determination of the ultimate aerobic biodegradability of plastic materials under controlled composting conditions - Method by analysis of evolved carbon dioxide-Part 1: General method, KS M ISO 14855-1, Korea Standard. (2013)
KS M ISO 14855-1, Determination of the ultimate aerobic biodegradability of plastic materials under controlled composting conditions - Method by analysis of evolved carbon dioxide-Part 1: General method, Korea Standard (2013).
Antibacterial activity assessment of textile materials - Parallel streak method, AATCC 147
AATCC 147, Antibacterial activity assessment of textile materials - Parallel streak method.
Y. Indrayani, D. Setyawati, T. Yoshimura and K. Umemura, Journal of Mathematical & Fundamental Sciences,
Decay resistance of medium density fibreboard (MDF) made from pineapple leaf fiber,
47(1); 76-83 (2015)
Indrayani, Y., Setyawati, D., Yoshimura, T., and Umemura, K., Decay resistance of medium density fibreboard (MDF) made from pineapple leaf fiber, Journal of Mathematical & Fundamental Sciences, 47(1):76-83 (2015).
10.5614/j.math.fund.sci.2015.47.1.6J. S. Park and K. Ikeda, Architectural Institute of Korea,
The Effect of formaldehyde emissions on fungal growth on the surface of wooden materials,
24(2); 1007-1010 (2004)
Park, J. S. and Ikeda, K., The Effect of formaldehyde emissions on fungal growth on the surface of wooden materials, Architectural Institute of Korea 24(2):1007-1010 (2004).
R. Nasser, M. M. A. Mansour, M. Z. M Salem, H. M. Ali and I. M. Aref, BioResources,
Mold invasion on the surface of wood/polypropylene composites produced from aqueous pretreated wood particles: Part 1: Date palm midrib,
12(2); 4078-4092 (2017)
Nasser, R., Mansour, M. M. A., Salem, M. Z. M,, Ali, H. M., and Aref, I. M., Mold invasion on the surface of wood/polypropylene composites produced from aqueous pretreated wood particles: Part 1: Date palm midrib, BioResources 12(2):4078-4092 (2017).
10.15376/biores.12.2.4078-4092C. A. Mooney, S. D. Mansfield, M. G. Touhy and J. N. Saddler, Bioresource Technology,
The effect of initial pore volume and lignin content on the enzymatic hydrolysis of softwoods,
64(2); 113-119 (1998)
Mooney, C. A., Mansfield, S. D., Touhy, M. G., and Saddler, J. N., The effect of initial pore volume and lignin content on the enzymatic hydrolysis of softwoods, Bioresource Technology 64(2):113-119 (1998).
10.1016/s0960-8524(97)00181-8P. Sannigrahi, S. J. Miller and A. J. Ragauskas, Carbohydrate Research,
Effects of organosolv pretreatment and enzymatic hydrolysis on cellulose structure and crystallinity in Loblolly pine,
345(7); 965-970 (2010)
Sannigrahi, P., Miller, S. J., and Ragauskas, A. J., Effects of organosolv pretreatment and enzymatic hydrolysis on cellulose structure and crystallinity in Loblolly pine, Carbohydrate Research, 345(7):965-970 (2010).
10.1016/j.carres.2010.02.010J. I. Boulter, J. T. Trevors and G. J. Boland, World Journal of Microbiology & Biotechnology,
Microbial studies of compost: Bacterial identification, and their potential for turfgrass pathogen suppression,
18; 661-671 (2002)
Boulter, J. I., Trevors, J. T., and Boland, G. J., Microbial studies of compost: Bacterial identification, and their potential for turfgrass pathogen suppression, World Journal of Microbiology & Biotechnology 18:661–671 (2002).
O. Stanojević, S. Milijašević-Marčić, I. Potočnik, M. Stepanović, I. Dimkić, S. Stanković and T. Berić, Arch. Biol. Sci,
Isolation and identification of Bacillus spp. from compost and mushroom casing soil active against Trichoderma spp,
68(4); 845-852 (2016)
Stanojević, O., Milijašević-Marčić, S., Potočnik, I., Stepanović, M., Dimkić, I., Stanković, S., and Berić, T., Isolation and identification of Bacillus spp. from compost and mushroom casing soil active against Trichoderma spp., Arch. Biol. Sci. 68(4):845-852 (2016).
H.-F. Lo, J.-Y. Su, H.-L. Chen, J.-C. Chen and L.-L. Lin, European Biophysics Journal,
Biophysical studies of an NAD(P)+-dependent aldehyde dehydrogenase from Bacillus licheniformis,
40; 1131-1142 (2011)
Lo, H.-F., Su, J.-Y., Chen, H.-L., Chen, J.-C., and Lin, L.-L., Biophysical studies of an NAD(P)+-dependent aldehyde dehydrogenase from Bacillus licheniformis, European Biophysics Journal 40:1131-1142 (2011).
10.1007/s00249-011-0744-xM. Eiroa, A. Vilar, C. Kennes and M. C. Veiga, Journal of Chemical Technology & Biotechnology,
Formaldehyde biodegradation in the presence of methanol under denitrifying conditions,
81(3); 312-317 (2006)
Eiroa, M., Vilar, A., Kennes, C., and Veiga, M. C., Formaldehyde biodegradation in the presence of methanol under denitrifying conditions, Journal of Chemical Technology & Biotechnology, 81(3):312-317 (2006).
10.1002/jctb.1395